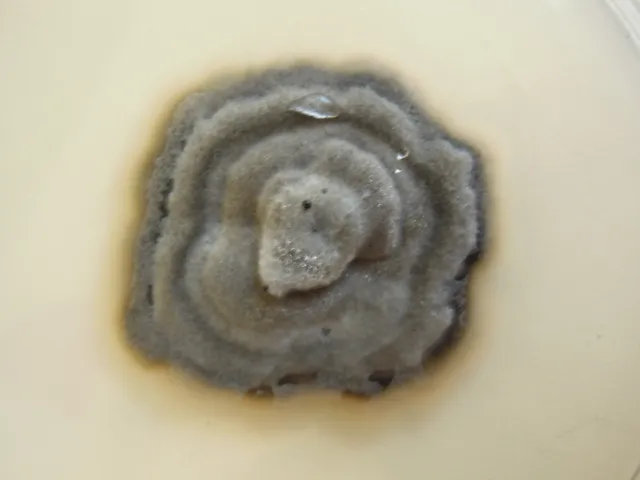

Navn og taksonomi
- Vitenskapelig navn:
- Leotiaceae
- Synonymer:
- Ingen
- Bokmål:
- Ingen
- Nynorsk:
- Ingen
- Nordsamisk/Davvisámegiella:
- Ingen
- Vitenskapelig navn ID:
- 67903
- Takson ID:
- 43876
Taksoner i artsgruppen
Registrerte funn

Laster funn i kart...
Registrerte funn i Norge
‐
Funn totalt
‐
Funn denne uken
‐
Funn i dag
Bilder av arter i artsgruppen
Siden siteres som
Artsdatabanken: Leotiaceae
Hentet fra https://artsdatabanken.no/arter/takson/43876